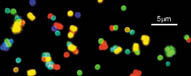

By tagging biomolecules like runners in a race, researchers can track complex interactions that occur in many biological arenas. Now, chemists report a scheme for creating a versatile color-based tagging system out of tiny atomic clusters, called quantum dots. The new method may enable scientists to track biomolecules with more finesse than ever.
The technique could boost by 100-fold the number of biomolecules, such as DNA and proteins, that scientists can monitor at one time, says Shuming Nie of the Indiana University in Bloomington. This capability, in turn, could lead to a deeper understanding of cancer and other diseases. Additional benefits of observing biological processes more fully may include improved drugs and accelerated discovery of functions of many genes and proteins, Nie adds. He, Mingyoung Han, and their colleagues describe their method in the July Nature Biotechnology.
The new method “gives us, for example, the ability to interrogate for the presence of many, many different [biomolecules] simply by looking at different colors,” comments Leroy Hood of the University of Washington in Seattle.
Currently, scientists create microscopic color codes with fluorescent dyes. First, they tint polymer spheres the size of bacteria with organic dye molecules. Then, they adorn those beads with custom-made DNA sequences or antibodies that, in turn, glom onto genetic material or protein molecules from pathogens, cells, or other targets. Researchers have been able to develop dyes in an assortment of colors, which they combine into several hundred dye-based codes. Yet there are many thousands of biomolecules that scientists want to track.
The rules of quantum mechanics enable the quantum dots (SN: 6/17/00, p. 392) to emit much more sharply defined colors than the dyes do. Also, the new method can formulate many thousands of codes with different combinations of colors and numbers of fluorescent atomic clusters in a bead. The more dots, the brighter the color.
The dots’ available colors and intensities should theoretically generate millions of tags, Nie says. However, subtle color-smearing irregularities among the quantum-dot tags cut that number down to tens of thousands, his team estimates. Notes David R. Walt of Tufts University in Medford, Mass., “Even that would be tremendous.”